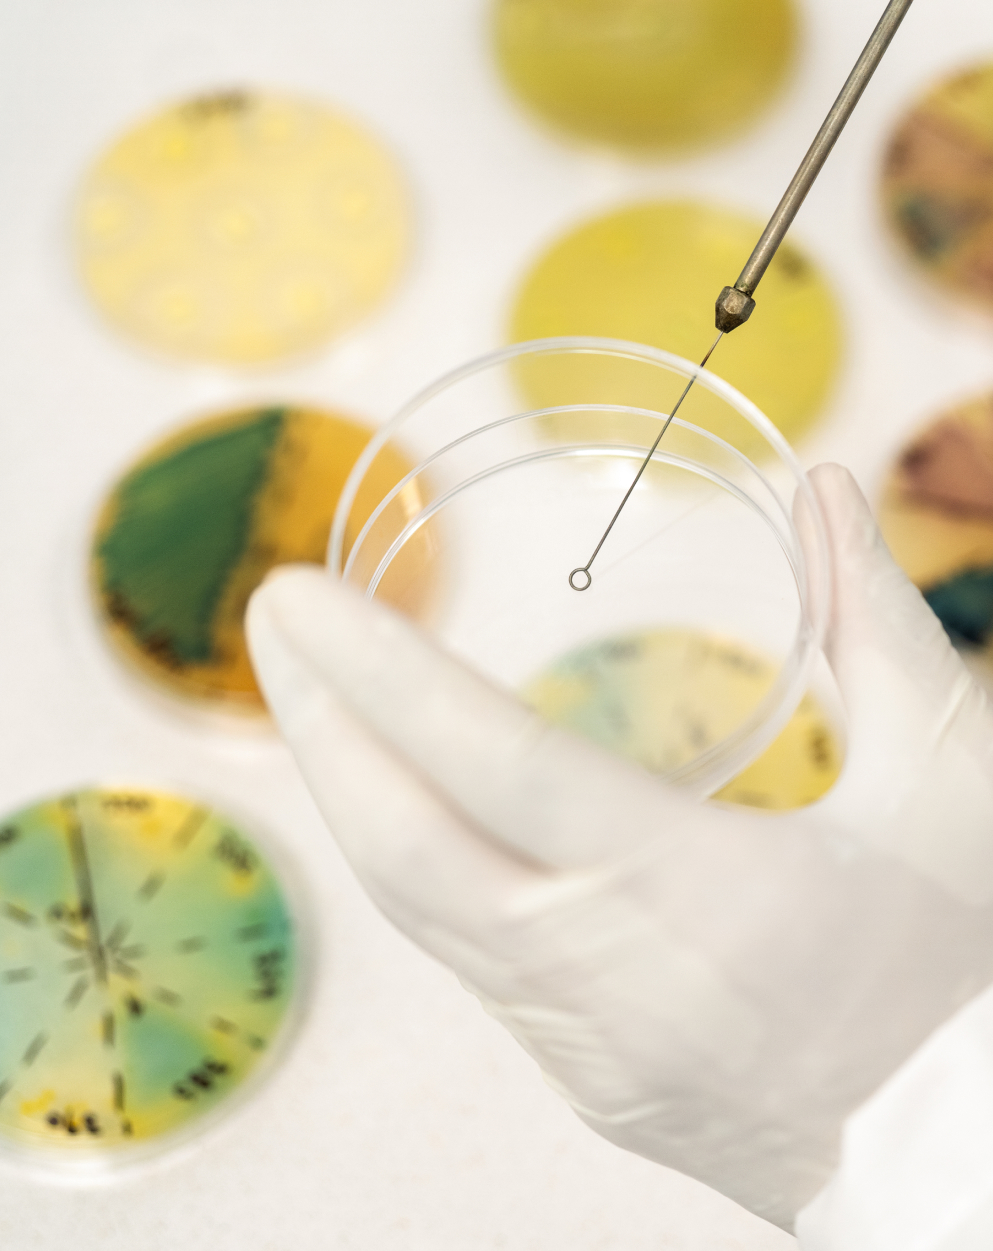

Expertise
From seed to success.
At Akay Bioactives, our value extends well beyond leading natural ingredients. We offer expertise to help you develop new solutions and overcome formulation challenges. Together, we can create breakthrough products that address consumer demand and meet strict regulatory standards.

By the numbers.
4
manufacturing facilities
50+
ingredients
2
R&D labs
70+
published scientific papers
6
proprietary delivery technologies
30+
patents (granted and applied)
Traceability & transparency
True partnership.
We believe deeply in partnership. It begins with our contract farming model. Akay Bioactives develops long-term relationships with the people and communities who grow our raw materials (both organic and conventional), collaborating on seed selection, cultivation, and harvesting practices. And our support of these partnerships continues with the help of our proprietary digital platform for tracking materials to the source.


Our specialized knowledge is complemented by the natural colors expertise of our parent company, Oterra. From raw materials we perform our own extractions, conduct in-house research and development, and offer formulation capabilities and regulatory expertise. We designed this unique end-to-end approach to help our customers get to market faster with complete trust in the quality and integrity of their finished product.
Manufacturing & quality
Deeply invested.


Our state-of-the-art facilities are located close to our sourcing partners to maintain quality control and reduce our environmental footprint. Our investment in green technology includes advanced systems that allow us to minimize waste by upcycling raw materials into sidestreams and fuel for other processes. We also employ clean extraction using water or natural solvents.

These types of proprietary and patented technologies help you develop differentiated, efficacious, sustainable, and clean-label products across a diverse range of applications.
Quality and safety matter most to us when it comes to manufacturing. We have rigorous quality and safety procedures in place across our entire operations to ensure full compliance with customer and regulatory requirements at every stage of the supply chain.


Research & development
Accelerating innovation.
Rely on our complete in-house R&D capabilities to help you deliver the most innovative, effective, and unique products in less time and with fewer roadblocks.
As your end-to-end partner, we offer formulation, discovery, clinical, and regulatory expertise. Work with our scientists in the way that works best for you, from concept development to co-creation and reformulation. We’ll help you get the best products to market, and we’ll help you get there first.
- 01 Extraction & standardization
- 02 Preclinical & clinical
- 03 Formulation & delivery
- 04 Regulatory

Advancing science and technology.
Delivery technology spotlight
We offer science-backed technologies that improve nutrient delivery and absorption, expand formulation opportunities to an array of formats, and taste-minimize ingredients to ensure no impact on organoleptic qualities of finished products. Because we know it’s crucial to deliver on the claims and applications that matter to the market.

FenuMat®
Patented 100% natural and sustainable hydrogel delivery technology that increases bioactive absorption and enables product formulation across a variety of formats.

FlavorOptix
Taste-masking technology for reducing the bitterness and pungency of botanical extracts.

HydroFlow
Natural technology transforming hydrophobic bioactives into cold-water dispersible forms with 90% to 95% purity.

CapColors®
Encapsulation of oil-soluble pigments and active ingredients for improved water solubility and bioavailability.

MaxFlow™
Proprietary technology for improving density, particle size, and flowability of botanical extracts.

CurcuLock™
Patented technology to produce non-leaching curcumin to prevent staining and dusting during processing.

Platform applications
Science spotlight
Science drives everything at Akay Bioactives because we believe in safe, proven ingredients that deliver validated health benefits. And it’s evident from the depth and breadth of our science that we’re committed to a level of rigor that few can match. We can back it all up.